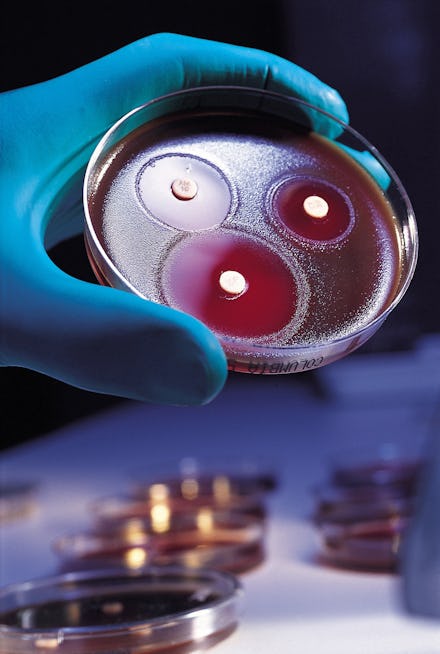

Your Genes May Be Part Mom, Part Dad and Part Bacteria
A good mom always knows to pack a little something extra — even when it comes to genetic material. According to a new study published online this week in Nature, the DNA of a mother's bacteria may be making its way into the genes of her offspring. This bacterial DNA may in turn affect the strength of our immune systems, the researchers report.
The study adds to a growing body of research that suggests there is much more to DNA than just what we get from our parents. It also shows that bacteria and viruses, often labelled as villains of health, may deserve more credit for the role they play in protecting our bodies and shaping our health.
The study: The researchers wanted to know why some mice were more susceptible to a gut-damaging chemical than others, and why that susceptibility seemed to spread so quickly between a community of mice. They traced the effect to a bacterium that suppresses a specific antibody that might otherwise equip a mouse to fight off the chemical's effect.
The only thing left for the team to do was figuring out how the bacteria spread. At first, they reasoned the mice might be catching the bacteria in the same way that people who share a combined space might pick up on one another's germs. But closer inspection showed the germ-sharing theory was only half true. Even before they had a chance to catch the bacteria from other mice around them, mice pups were being born with a decreased amount of the antibody and for researchers, that meant one thing: The pups were inheriting the trait.
"We wanted to understand how an alteration of the immune system (immunoglobulin A in the gut) that is normally caused by genetic mutations in the host (in this case mice) could be present in 'normal' mice," coauthor Thaddeus Stappenbeck, a developmental biologist at Washington University in St Louis told Mic. "We found that the key genes driving this were located not in the host, but in bacteria. We then found that these bacteria could essentially be inherited from the mom," he added.
The study shows that phenotypic effects (observable physical or biochemical characteristics determined by both genes and environment), can be transmitted from organisms, like bacteria, that naturally live within our body and alter the genes that we pass on, the team writes.
The good, the bad, the immunity: Anyone who has enjoyed a probiotic yogurt knows that not all bacteria are bad for us, but scientists are still unravelling the mystery of how the good ones squatting harmlessly in our bodies may fit into the way it functions. This study indicates that they might not just be stowing away after all, but could actually be making their way into the very fiber of our being.
Even though the study only looked at mice, this research marches us one step closer to understanding how a woman affects the health of her child right from the moment of conception. It also acts as a heads up for the scientist that rely on mice to study human conditions that affect the gut. Now, knowing that there may be an interplay between bacteria and our genes, scientists might be able to tighten up their experimental settings and ensure that there aren't huge differences between the mice that they use for a study.
Perhaps most importantly, the study may finally lay to rest the question of whether you take more after your mother or your father. The conclusion? Moms for the win.